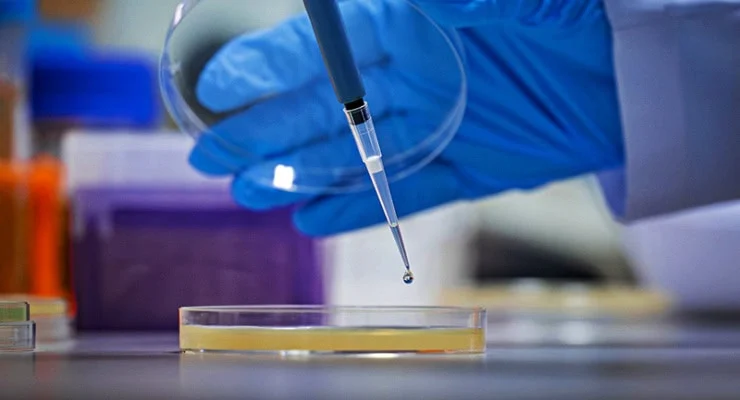

İspanyol bilim insanlarının araştırması bir bakteri türünün salgıladığı proteinin kanser hücrelerini yok ettiğini ortaya çıkardı.
Kanser hücrelerinin kendi kendisini yok etmesine olanak sağlayan protein, HapA adıyla biliniyor. Vibrio cholerae adlı bakteri tarafından salgılanıyor.
Bilim insanları bu bakteriyi meme, kalın bağırsak ve pankreas tümör hücrelerinde test etti.
Araştırmacılar HapA proteininin gerçekten kanser hücrelerini öldürüp öldürmediğini test etmek için, HapA üretmeyen ‘mutant Vibrio cholerae’ türleriyle, sadece HapA üretecek şekilde ‘genetik olarak değiştirilmiş bakterilerle’ deneyler yaptı.
Yalnız HapA proteininin bulunduğu ortamda tümör hücrelerinin azaldığı görüldü. Araştırma sonuçları bakterilerin tedavi potansiyeli taşıdığı gösterdi.
Kanser hücrelerini yok eden protein
HapA proteini, tümör hücrelerinin yüzeyindeki iki temel reseptör ‘PAR-1’ ve ‘PAR-2’de etkili. Bu reseptörler genellikle tümör büyümesi, iltihaplanma ve kan pıhtılaşmasıyla ilişkili.
Dolayısıyla bakterinin ürettiği HapA kanserli hücreyle temas edince hızlı bir şekilde ‘apoptoz (programlanmış hücre ölümü)’ sürecini başlatıyor.
Araştırmanın sonuçları bilim dergisi Cell Death Discovery’de yayınlandı.